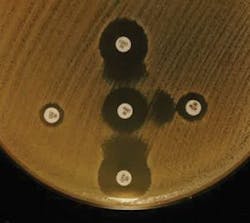
Mlospfe Image1 300x267 Mlospfe Image1 300x267

The beauty of disk diffusion susceptibility testing—a legacy not to be forgotten
Back in the early 90s when I started my career in clinical microbiology, the only automated susceptibility system in my laboratory was the Vitek Legacy. Needless to say, for a young aspiring microbiologist, it was a very convenient way of staying lazy, where mostly everything was put into the Vitek for identification and susceptibility. While some disk diffusion and gradient-method testing were done to an extent (i.e., susceptibility of fastidious organisms, and in instances that we wanted to confirm the results of the automated system), I would say that Vitek was the workhorse of our laboratory.
Connecting the Vitek results with the hospital/laboratory LIMs (Laboratory Information Management System) and releasing the microbiology results electronically was a convenient way of doing microbiology and made my job a breeze. Every day I was on autopilot where the priorities were to load the Vitek cards and release the results in batches. However, the easy life didn’t last long when emerging mechanisms of resistance started to get broadcasted in conferences, and these esoteric resistance mechanisms demanded additional confirmatory tests.
I recall at one of the American Society for Microbiology conferences, in a talk by Dr. Ken Thomson (at that time affiliated with Creighton University), it was emphasized about the relevance of a special mechanism called Extended-Spectrum β-Lactamases; and how important it needed to be called out because of its importance for therapeutic purposes. It was alarming to know that even in instances where an organism may appear susceptible to a broad spectrum cephalosporin, it may be ineffective in vivo, and that amending susceptibility results was necessary. What also didn’t help was that it may be tangled up with other mechanisms such as AmpC (other type of β-Lactamase) within the same organism. Because of these special mechanisms, and because the automation was still in its infancy about designing special “flagging” or expert comments, our laboratory adopted disk diffusion testing in parallel to the automation in all sterile site cultures and when additional confirmation was required, gradient system was also performed when deemed necessary. If asked, I would say that this was the turning point of my microbiology life where I turned from a mundane microbiologist into a susceptibility freak.
Reading Kirby-Bauer plates then became the highlight of my daily routine where I would carefully scour through stacks and stacks of Mueller Hinton plates looking for Enterobacteriaceae with unusual zone sizes and susceptibility patterns, and cross-reference with the Vitek Legacy results. When pertinent, I would also perform additional confirmatory tests to affirm/deny the suspicions. I recall I devoured every paper about β-Lactamases; all Thomson et al papers, the classic Bush-Jacoby-Medeiros publications, etc., and papers from the Europeans scholars such as Alain Philipon and David Livermore; and even contacted Dr. Thomson when I encountered my first ESBL (extended-spectrum β-lactamase). Encountering my first ESBL experience was so thrilling that it can be compared to a child seeing Mickey Mouse for the first time at Disneyland!
Of course, life in a routine microbiology laboratory wasn’t solely about finding ESBL at all costs those days. It was also about learning to pick up the nuances of all other emerging mechanisms at the age that the expert system of the automated methods were limited. In essence, reading manual susceptibility methods require a heightened sense of acuity because when small nuances are missed, a resistant organism may go undetected.
From an antimicrobial susceptibility testing (AST) geek’s standpoint, disk diffusion (also known as Kirby Bauer testing) is an art. It is more than just placing disks and measuring the zone sizes. It is about knowing enough about the bacteria in question, placing the disks strategically to predict the possible mechanism(s) of resistance using indicator drugs, and interpreting judiciously each nuance according to potential phenotypic clues and patterns. In addition, the combination of (1) knowing the intrinsic resistance patterns by genus or group of bacteria, and (2) knowing the unusual patterns serve to aid (or rule out) genus/species in the identification process.
Below illustrates some instances where the resistance patterns have helped in the troubleshooting/identification process, and also some anecdotal moments of my life as a bench microbiologist.
For instance, a Klebsiella that showed susceptibility to ampicillin, probably wasn’t a Klebsiella and a re-identification may have been warranted. An identification-confirmed Klebsiella pneumoniae with reduced susceptibility to cefoxitin may suggest porin mutation or acquisition of plasmid-coded AmpC β-Lactamase. Same applies to E. coli where cefoxitin resistance was somewhat unusual and mostly related to the same described mechanisms.
A strain belonging to Enterobacter cloacae, Enterobacter aerogenes (now newly named as Klebsiella aerogenes) or Citrobacter freundii group will virtually always present full resistance to ampicillin, cephalothin, and cefoxitin due to low level of chromosomal AmpC enzyme expression. When the AmpC is expressed in higher level (derepressed) it will predictably confer resistance to all 3rd generation cephlosporins except cefepime. In case a reduced susceptibility to cefepime is observed in these species, it is likely that plasmid-coded ESBL may also be present.
At that time carbapenem resistance was unheard of, hence all Enterobacteriaceae with reduced susceptibility to imipenem and meropenem (the only carbapenems available at that time) were certainly scrutinized. I even recall the first time a carbapenem insusceptible Klebsiella came across my bench (MIC to imipenem of 4 µg/mL). It was certainly quite an eye-opener, and I even contacted Dr. David Livermore from UK’s Health Protection Agency for confirmation.
A few other useful “tricks” I had under my sleeve when working on the bench were:
- A Moraxella catarrhalis that tested negative for ββ-Lactamase is probably not a catarrhalis because over 90 percent of M. catarrhalis are β-Lactamase producers.
- Stenotrophomonas maltophilia must be resistant to all ββ-Lactams and aminoglycosides.
- It is acceptable to sometimes see Proteus with reduced susceptibility to imipenem, but not to meropenem.
- Also, Proteus are mostly resistant to polymixin/colistin, tetracycline, and nitrofurantoin.
- Enterobacteriaceae (other than Proteus/Providencia/Morganella), Pseudomonas and Acinetobacter that are insusceptible to polymixin/colistin absolutely need further confirmation.
- Organisms that confer resistant to nalidixic acid may be prone to develop further resistance to higher generation fluoroquinolones, a process called step-wise mutation.
- A beta streptococci that’s resistant to penicillin needs to be further scrutinized.
- Needless to say, a vancomycin resistance in Staphylococcus aureus will most likely get someone’s attention and will often indicate degradation of the AST methodology. However, other than vancomycin resistant enterococci (VRE), all Gram positive cocci that are resistant to vancomycin are probably Leuconostoc, Vagococcus, or Pediococcus.
About vancomycin—I can candidly share one of the most embarrassing moments of my life as a young microbiologist. During a routine afternoon in the lab where every one of us was working away and releasing culture results, I noted a white colony inside of a vancomycin disk’s inhibition zone of a lawn of S. aureus (at that time, there was CLSI vancomycin disk criteria for Staph). The adrenaline rushed, and obviously I thought I had found a vancomycin resistant S. aureus. Out of breath from running a few stories to the medical director’s office with my findings, the wise doctor received my verbal report with skepticism, and said, “Son, please do a Gram stain of that colony, will you?” The Gram stain revealed a yeast-like structure, surely a contaminant of that Kirby Bauer plate. Obviously, I just wanted to dig a hole and never return to the boss’ office ever again. As the time went by, my fondness for AST increased, the wise doctor took a liking of my eagerness (or foolishness) and mentored my growth, as he was also very interested in the subject and involved in a wide variety of resistance-related projects. For the next few years we were enthusiastically immersed in several antimicrobial surveillance studies.
Obviously, the story above predates bulk of Carbapenem resistance that was reported in the early 2000s. At that time, in the mid 90s, the CLSI M100 document did not contain the wealth of details that it contains today. Hence a lot of my “tribal knowledge” came from information gathered from publications, data from the surveillance studies, and conferences. The M100 document of today contains a much more comprehensive amount of information, interpretation guidance, and new recommendations that caters to most of microbiologists’ AST needs. To my knowledge, one of the main challenges of today is in the standardization of colistin/polymixin resistance detection. The CLSI committee meets twice year and I am quite certain more recommendations about colistin/polymixin are on the horizon.
Nostalgically, I recall about 10 years ago, a chat I had with the late Dr. Paul Schreckenberger; he showed me the importance of the disk placement strategy of his 12-disk test. After listening to him, I proudly told him that I had devised a similar method of my own (a slight variant of his method) a few years before, with key indicator drugs that could simultaneously detect most of mechanisms encountered in Enterobacteriaceae. Dr. Schreckenberger was proud of me. He was a dear friend and I miss him tremendously.
For the past few years, a rebirth of disk testing has been highlighted due to the spurt of approval of new antibiotics by the FDA. Since 2014, several antibiotics such as ceftolozane-tazobactam, ceftadizime-avibactam, meropenem-vaborbactam, delafloxacin, and plazomicin have been approved, and the susceptibility disks followed suit a few months after the drug approval. The reasoning behind this is because the disk is the most straightforward medical device to impregnate the antibiotic, whereas the development of automated devices (MIC methods) is lengthier and so is the FDA assessment/clearance period. With absence of the automated methods, the introduction and testing of disks is critical to optimize the clinical outcome.
As a middle-aged microbiologist that has transitioned from the clinical laboratory to the microbiology device industry, I cannot emphasize enough the appreciation, the beauty, and the criticality of understanding the basics of mechanism of resistance in addition to the judicious performance and interpretation of manual susceptibility methods. My days reading stacks of Kirby-Bauer plates are behind me, but it was certainly an important and precious learning experience to me, and I would not hesitate to encourage younger generations of clinical microbiologists to venture into this journey. Those zone sizes will certainly speak to you more than you imagine.
This article is in remembrance of late Dr. Caio Mendes, who was a beloved mentor and friend. He showed me the passion for microbiology/AST, the love for fine wines, and the power of networking.